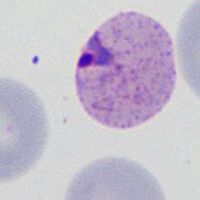
C

Accolé form description
From MalariaETC
| Navigation |
| >Previous Page |
| Accolé form
Accolé forms (also be referred to as "edge" or “appliqué” form) are parasites from early or late trophozoite stage where the parasite is closely opposed to the edge of the erythrocyte - usually appearing to be flattened against the membrane.
Note that the parasite is very closely in contact with the red cell membrane (P.falciparum late trophozoite form with Maurer's dots and clefts)
Species significance Most often considered to be a feature of P.falciparum infection and when frequent these appearances are helpful to indicate this species. However, the form is not fully specific and examples may occur in any species. Additional images
Malaria accolé forms in: early trophozoite of P.malarae (A) early trophozoite of P.vivax (B) and early trophozoite of P.ovale (C). Note the differences in parasite and red cell size and shape and the presence or absence of additional dots |